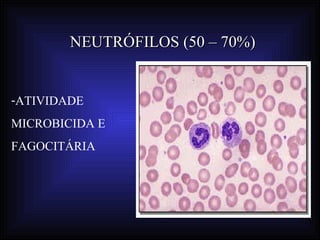
NEUTRÓFILOS (50 – 70%)


-ATIVIDADE
MICROBICIDA E
FAGOCITÁRIA

O documento aborda o sistema imunológico, destacando a imunidade inata e adquirida, seus componentes e mecanismos de resposta a patógenos. Ele discute a importância das barreiras naturais, como pele e mucosas, a função dos diferentes tipos de células sanguíneas e a atuação de anticorpos. Também menciona doenças autoimunes e hipersensibilidades como reações do sistema imune que podem causar danos ao organismo.